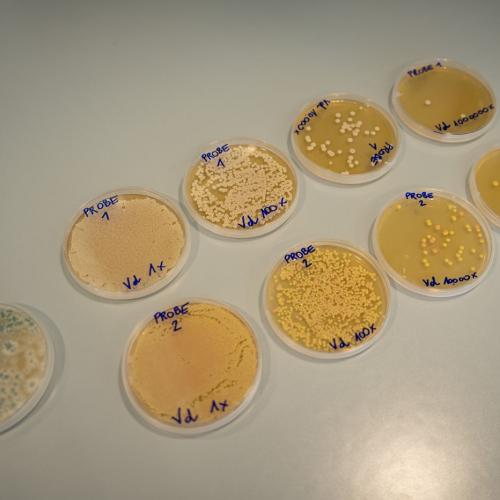
Sandoz

Mit „klasse!forschung“ zur Sandoz
Am Faschingsdienstag hatten wir die Gelegenheit, gemeinsam mit interessierten SchülerInnen der 4. Klassen die Firma Sandoz zu besuchen. Dort wurden uns zwei spannende Fachbereiche vorgestellt.
Im chemischen Labor durften unsere SchülerInnen selbst experimentieren – sie arbeiteten mit mikrobiellen Proben und verschiedenen Lösungen, um spannende Erkenntnisse zu gewinnen. Im mechatronischen Labor tauchten sie in die Welt der Technik ein: Sie programmierten Schaltungen und testeten diese direkt an physischen Bauteilen.
Dieser praxisnahe Einblick begeisterte unsere SchülerInnen und weckte großes Interesse an naturwissenschaftlichen und technischen Berufen.
Fotos: Andreas Moser